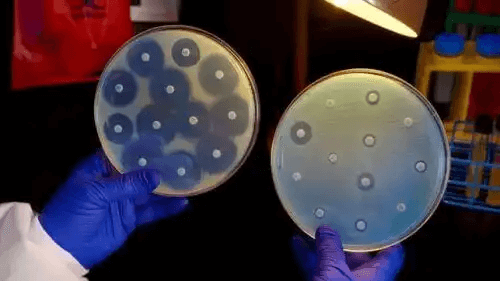

Hur man kan förhindra antibiotikaresistens

Antibiotikaresistens är ett av de mest allvarliga problemen i världen idag. Det beror på att fler och fler infektioner blir resistenta mot antibiotikabehandling i en oroande snabb takt. Därför är det viktigt att tänka på hur man kan förhindra antibiotikaresistens.
Uppskattningar tyder på att denna typ av resistens växer exponentiellt. Detta beror till stor del på felaktig användning av antibiotika, som människor ofta använder alltför ofta. Vi har nått en punkt där många behandlingar för bakterier inte längre är effektiva.
Denna situation är farlig eftersom vi blir mer och mer försvarslösa mot olika infektionssjukdomar. Problemet kräver individuella, kollektiva och statliga åtgärder för att förhindra att det blir värre.
Vad är antibiotikaresistens?
Det är den mekanism genom vilken bakterier minskar effekten av de medel vi använder för att bekämpa dem. Det är en process som är baserad på naturligt urval och genetisk anpassning som gör att dessa mikroorganismer står emot vissa läkemedel.
Man säger att antibiotikaresistens uppstår när koncentrationen av ett antibakteriellt ämne är fyra gånger högre än den lägsta hämmande koncentrationen (MIC). Med andra ord när bakterien har en fyrdubbling i förmågan att neutralisera angriparen.
För närvarande är hastigheten med vilken nya resistenta organismer uppträder högre än den hastighet med vilken nya läkemedel blir framtagna. Vi har därför ett underskott som fortsätter att växa och lämnar oss i en komprometterande situation när vi vill behandla gamla och nya infektionssjukdomar.
Typer och mekanismer för antibiotikaresistens
Det finns två typer av antibiotikaresistens. Den ena är naturlig, det vill säga den är en del av själva bakteriens natur. Den andra uppstår när genetiska mutationer som avvisar antibiotika uppstår. Sådana mutationer kan i vissa fall överföras till andra bakterier, även de från andra arter.
Det finns flera mekanismer för antibiotikaresistens:
- Den första är den aktiva utdrivningen av bakterierna, som fungerar som en slags utmatningspump
- Den andra mekanismen är minskningen av permeabiliteten hos bakterieväggen (till exempel ökningen av åtkomstbarriärer för bakterien)
- Den tredje mekanismen är produktionen av enzymer som gör antibiotika inaktiva. Detta innebär att de hämmar den normala effekten av läkemedlet och gör det ineffektivt
Vi rekommenderar även att du läser den här artikeln: 4 naturliga antibiotikabehandlingar för halsinfektioner
Strategier för att förhindra antibiotikaresistens
Den första strategin för att förhindra antibiotikaresistens är att förebygga infektioner. Detta kan man till stor del uppnå genom grundläggande åtgärder som frekvent handtvätt, korrekt hygien vid matlagning, undvika kontakt med de smittade, ha säkert sex och hålla sina vaccinationer uppdaterade.
Här vill vi också notera vikten av korrekt hygien vid matlagning. Världshälsoorganisationen (WHO) pekar ut fem nycklar för att göra det:
- Håll utrymmena i köket och alla redskap rena
- Separera råa livsmedel från tillagade livsmedel
- Använd dig av rutiner för att upprätthålla hygienen för livsmedel när du lagar mat
- Förvara maten vid rätt temperatur
- Använd rent vatten och råvaror som inte är skämda
Samtidigt är det viktigt för människor att bara ta antibiotika när de ordinerats av en läkare och inte självmedicinera. Vi bör också följa läkarens instruktioner angående scheman och doser.
Det är inte tillrådligt att avbryta behandlingen även om du mår bättre. Det finns en risk att mer resistenta bakterier kan utvecklas om du inte tar den ordinerade mängden medicin.

Vi rekommenderar även att du läser den här artikeln: Korskontaminering från skadliga virus och bakterier
Andra åtgärder för att förhindra antibiotikaresistens
Jordbruksarbetare bör endast använda antibiotika på djur under strikt övervakning av en veterinär. Detta eftersom att olämplig användning av dessa ämnen i jordbruket eller djurhållningen är en av huvudorsakerna till antibiotikaresistens. Det sprider sig till miljön och till människor genom näringskedjan.
Hälso- och sjukvårdspersonal bör också vidta extrema kontrollåtgärder i detta avseende. Forskare har upptäckt att läkare skriver ut 50 % av antibiotika för virussjukdomar, trots att de inte borde göra det. Faktum är att de bara ska skriva ut antibiotika om det finns en garanti för att dessa är absolut nödvändiga.
Myndigheter och oberoende institutioner bör vara vaksamma för ett utbrott och avgöra om det handlar om en bakterie som är resistent mot antibiotika så snabbt som möjligt. Det är också viktigt att de informerar och utbildar medborgarna om det bästa sättet att förebygga infektionssjukdomar.
Det är nödvändigt för forskare och läkemedelsindustrin att samarbeta för att intensifiera studier i detta ämne. Hela världen borde stödja forskning om detta eftersom mycket av vårt välbefinnande och framtid beror på det.
Samtliga citerade källor har granskats noggrant av vårt team för att säkerställa deras kvalitet, tillförlitlighet, aktualitet och giltighet. Bibliografin för denna artikel ansågs vara tillförlitlig och av akademisk eller vetenskaplig noggrannhet.
- Alós JI. Resistencia bacteriana a los antibióticos: una crisis global [Antibiotic resistance: A global crisis]. Enferm Infecc Microbiol Clin. 2015 Dec;33(10):692-9.
- Wencewicz TA. Crossroads of Antibiotic Resistance and Biosynthesis. J Mol Biol. 2019 Aug 23;431(18):3370-3399.
- Davies J, Davies D. Origins and evolution of antibiotic resistance. Microbiol Mol Biol Rev. 2010 Sep;74(3):417-33.
- Huemer M, Mairpady Shambat S, Brugger SD, Zinkernagel AS. Antibiotic resistance and persistence-Implications for human health and treatment perspectives. EMBO Rep. 2020 Dec 3;21(12):e51034.
Denna text erbjuds endast i informativt syfte och ersätter inte konsultation med en professionell. Vid tveksamheter, rådfråga din specialist.